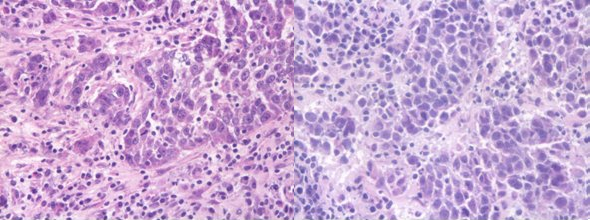

|
|
|
| Une procédure de diagnostic ex-temporané fiable et rapide |
| |
Un histo-diagnostic extemporané précis et rapide est critique pour la décision de la poursuite chirurgicale alors que le patient est encore au bloc opératoire. Les procédures extemporanées se développent rapidement avec les objectifs de réduire ou éliminer le recours au rappel du patient au bloc opératoire tout en lui donnant plus de chances de guérison avec une chirurgie plus efficace dès la première intervention.
Alors que de nombreuses études qualifient les diagnostics extemporanés d’une fiabilité d’environ 90%, la plupart des laboratoires reconnaît néanmoins que la qualité des coupes congelées est souvent mauvaise pouvant introduire des erreurs d’interprétation.
Alors que la plupart des coupes congelées sont obtenues après une congélation à des températures allant de -50°C à -28°C, ce niveau de température est reconnu pour être tout à fait insuffisant pour une excellente qualité de coloration et donc de diagnostic.
Une température de congélation trop élevée engendrer la formation de cristaux suffisamment gros pour entraîner des dommages dans les membranes tels que colorant et contre-colorant se mélangent rendant la discrimination des cellules et des structures histologiques plus difficile.
En alternative, la congélation rapide en isopentane refroidi à -80°C a été largement publiée depuis plusieurs décennies comme démontrant la meilleur morphologie et la meilleure qualité moléculaire à cause de 2 raisons principales : 1) -80°C est une température suffisamment basse pour empêcher la formation de cristaux de taille dommageable aux tissus 2) contrairement à l’azote liquide, l’isopentane ne dégaze pas au contact du spécimen et de ce fait élimine les risques de fractures qui sont autant de possibilités de dégradation. SnapFrost® 80 d’ALPHELYS est une solution très efficace, performante, confortable et sécurisée pour la congélation rapide tous les jours pour le diagnostic extemporané ou les banques de tissues. |
| |
|
Coupe en H&E de vessie humaine.
Droite: congélation sur une barre rapide d’un cryostat à -40°C (meilleur résultat obtenu)), Gauche: congelé avec SnapFrost® à -80°C en isopentane. |
|
| |
| La recherche sur le Cancer et le profilage tumoral demandent un contenu moléculaire de grande qualité |
| |
|
La plupart des spécimens inclus en banques ont été congelés en azote liquide. Bien que la très basse température apportée par l’azote liquide soit bénéfique pour éviter les dégâts des cristaux, l’azote liquide présente néanmoins un inconvénient majeur : il dégaze violemment au contact du spécimen à cause de la chaleur apportée par ce dernier, transformant l’azote liquide en azote gazeux. Cette transition brutale est bien connue pour engendrer des fractures dans les tissus qui sont autant d’opportunités de dégradations immédiates et dans le long terme lors du stockage et à la décongélation du spécimen en vue de son utilisation.
En alternative, la congélation en isopentane refroidi à -80°C procure une procédure efficace et reproductible, largement publiée, qui garantit haute qualité morphologique et moléculaire.
Le « SnapFreezer » SnapFrost® d’ALPHELYS apporte la solution instrumentale pour des conditions de congélation contrôlées et sécurisées pour des opérations quotidiennes. |
 |
| |
|
| SnapFrost® : Le “Snap Freezer” |
| |
 |
 |
| |
| SnapFrost® est un équipement très compact dont les dimensions s’adaptent parfaitement à l’utilisation en laboratoire de pathologie notamment. Utilisant des compresseurs électriques pour refroidir l’isopentane à des températures ultra-basses, SnapFrost® est totalement indépendant de l’utilisation d’azote liquide ce qui r end cet instrument très sécurisé d’utilisation, sans besoin d’environnement dédié. La température est précisément et en permanence contrôlée pour garantir une parfaite reproductibilité de la qualité de vos spécimens congelés. |
|
|
| |
| |
| SnapFrost®: adapté pour tous formats de spécimens... |
| |
SnapFrost® est bien adapté pour tous formats de spécimens que vous souhaiteriez congeler : par immersion directe, sur support de cryostat, en cryomold (cryosette), en cryotube…la chambre de congélation est d’un volume suffisamment large pour répondre à tous vos besoins de congélation rapide.
Pour le diagnostic sur coupe congelée, le spécimen est rapidement congelé en quelques secondes directement en OCT sur le support de cryostat. Une fois congelé, le spécimen est transféré au cryostat pour s’équilibrer en 1 minute à la température de coupe. |
| |
|
| …pratique d’utilisation et de besoin de maintenance limité |
| |
SnapFrost® propose une chambre à deux compartiments : celui du bas contient l’isopentane, il est régulé à -80°C et est utilise pour la congélation rapide. Le compartiment du haut est régulé à -40°C et est utilisé pour stocker temporairement les spécimens congelés durant la séance de congélation et en attente de leur transfert vers les congélateurs ou le cryostat.
La maintenance se limite au nettoyage annuel de l’entrée d’air des compresseurs.
Le nettoyage de la chambre de congélation se fait à l’aide d’un chiffon imbibé d’alcool à 70%.
L’isopentane est un réactif facilement disponible et peu coûteux. |
| |
| Des hôpitaux, des laboratoires de recherché, des laboratoires pharmaceutiques, ou encore des banques de tissues ont choisi SnapFrost® |
| |
|
| Hôpital Universitaire Bicêtre, Paris, France, Hôpital Universitaire Brousse, Paris, France, Hôpital Universitaire Rennes, France, Inserm, Bordeaux, France, Hôpital Universitaire Lille, France, Hôpital Universitaire Sart-Tilman, Liège, Belgium, University Hospital, Zürich, Switzerland, University Hospital Berlin Charite, Germany, Bayer, Germany, University Hospital Oxford, UK, Beijing University, China, Astra Zeneca, Sweden, Carver Iowa University Hospital, USA, ... |
 |
| |
|
| Littérature |
| |
| Steu, S., M. Baucamp, G. von Dach, M. Bawohl, S. Dettwiler, M. Storz, H. Moch, and P. Schraml, A procedure for tissue freezing and processing applicable to both intra-operative frozen section diagnosis and tissue banking in surgical pathology. Virchows Arch 2008. |
| |
| Télécharger la démonstration |
| |
|
|
|
ALPHELYS,
Ferme des Ebisoires, Impasse Paul Langevin, 78370 Plaisir - France
Tél +33 (0)1 30 07 52 95 - Fax +33 (0)1 30 07 51 56 - eMail
info@alphelys.com
Copyright © 2001/2011 ALPHELYS, all rights reserved.
|
|
|
|
|